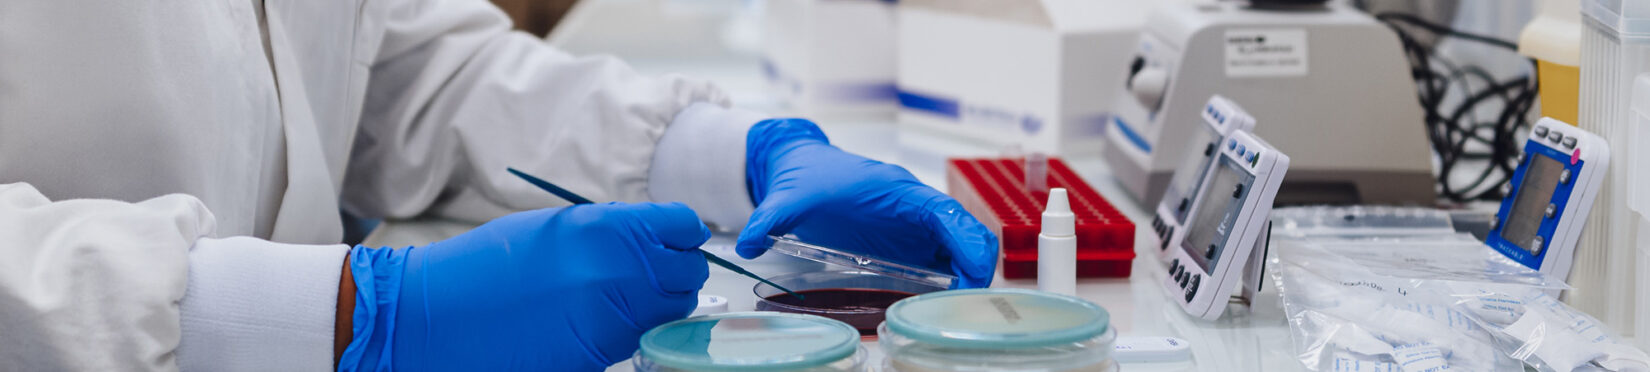
L1080039

Une PME bretonne de biotechnologies qui grandit avec ses talents
A French biotech company growing together with its talents
Située au sud de Rennes, notre PME bretonne en forte croissance développe, fabrique et distribue ses produits dans le monde entier. Portée par des valeurs fortes – esprit d’équipe, bienveillance et engagement – nous plaçons nos collaborateurs au cœur de notre croissance et de notre réussite à long terme.
Based south of Rennes, our fast-growing French biotech company develops, manufactures and distributes its products worldwide. Guided by strong values – teamwork, care and commitment – we place our employees at the heart of our growth and long-term success.